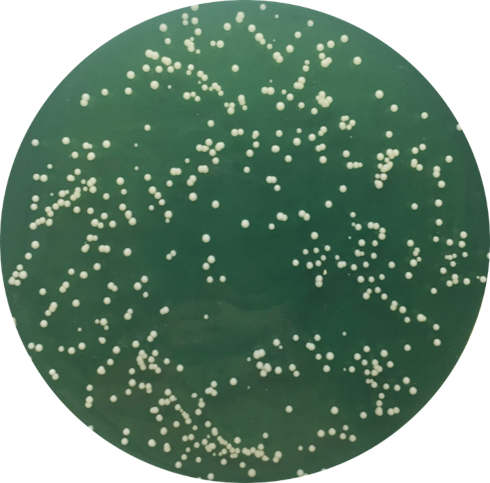

Fecal Microbiota Transplantation (FMT): A little too much Candida do more harm than good?
Published in Microbiology
The FMT team at the Chinese University of Hong Kong led by Prof Siew Ng and her post doc scientist Tao Zuo have discovered that the presence of Candida albicans compromises FMT efficacy in patients with Clostridium difficile infections. High abundance of C. albicans in recipient or in donor feces nullifies FMT efficacy in CDI whereas antifungal treatment to eradicate C. albicans restored FMT efficacy in mice. These data suggest that the presence of C. albicans leads to unfavourable FMT outcome.
An old concept resurfaces
In the Fourth century in China, a "yellow soup" (aka "golden syrup") made from fresh, dry or fermented stool was used to treat food poisoning and abdominal diseases. This is the first effort of what is now called Fecal Microbiota Transplantation (FMT). FMT has revolutionized the treatment of a bacterial infection, Clostridium difficile infection. It involves the transfer of gut microbes from a healthy donor to a recipient and is over 90% effective for treating antibiotic-resistant C. difficile infection.
FMT goes viral
FMT has gained much popularity worldwide. Clinical trials are testing its efficacy in inflammatory bowel disease (IBD), irritable bowel syndrome (IBS), obesity, autoimmune diseases, autism and many more. Until now, the mechanisms underlying the efficacy of FMT are largely unknown and success was ascribed to the restoration of the gut bacterial microbiota similar to that of the donor.

Our findings
At the Chinese University of Hong Kong, we have treated over 100 patients with recurrent Clostridium difficile infections (CDI) using FMT since 2016. Recently, our faculty developed a FMT stool biobank to facilitate FMT treatment. With the advent of high-throughput sequencing technologies and emerging knowledge of importance of the “dark matters” of gut microbiota, we are interested in whether donor and recipient mycobiota profile impact FMT outcomes.

In our recent study published in Nature Communications (https://www.nature.com/articles/s41467-018-06103-6), we reported fungal “dysbiosis” or alterations in patients with Clostridium difficile infection. Interestingly, cure of CDI after FMT was observed when the donor-derived fungal taxa predominated in the recipient mycobiota. Subjects who responded to FMT showed a high prevalence of Saccharomyces and Aspergillus whilst those who did not had a dominant presence of Candida. Moreover, high abundance of C. albicans in recipient or in donor stool nullifies FMT efficacy in CDI. In contrast, using antifungal treatment to eradicate C. albicans could restore FMT efficacy in mice.
Candida albicans colonies
Epidemiological studies showed that antibiotic exposure is associated with fungal bloom. Urban residents had a higher prevalence of gut C. albicans colonization than rural residents. The rapidly changing environmental factors with frequent antibiotics use during urbanization may contribute to the rising prevalence of C. albicans.
With the booming in FMT practice worldwide ranging from highly organized stool bank programmes to individual treatments with patient-identified and directed donors, our findings highlight the importance of the gut fungi in FMT efficacy. The future of FMT should take into consideration detailed characterization of both recipient and donor fecal mycobiomes and optimization of donor selection for a more personalized approach to FMT.
These data have potential impact on the use of FMT in the treatment of other human diseases. It also sets a new direction in FMT research that may lead to a paradigm shift in patient care. In the future, fecal fungome profiling (along with bacteriome and virome profiling) in both donors and recipients may become an essential part of clinical protocol for FMT. Much more work is required to find the level where common health effects are manifesting in the gut mycobiota and how such features could be used to improve human health, but these results provide further support that such features might exist.
Please sign in or register for FREE
If you are a registered user on Research Communities by Springer Nature, please sign in